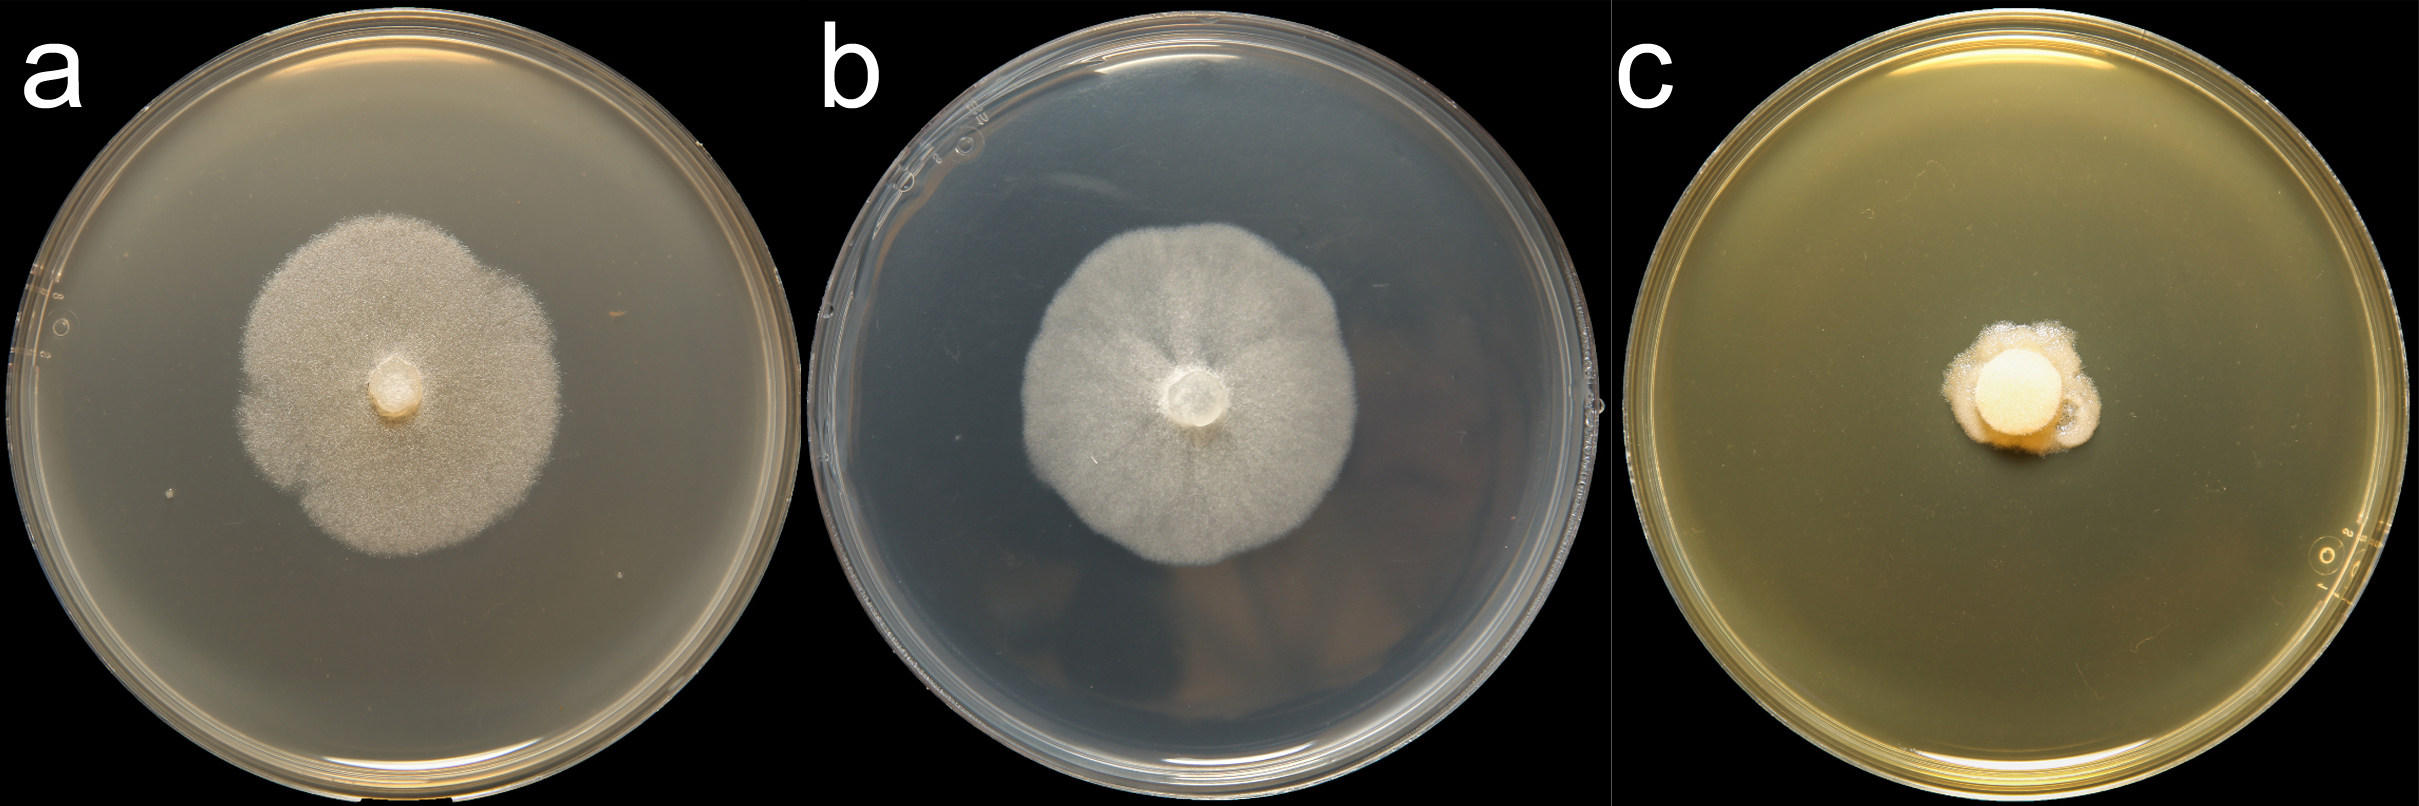

Phytophthora primulae (in progress - Abad et al. 2023b)
|
Phytophthora spp. in subclade 8b: portion of the seven-loci ML phylogeny featuring the type cultures of 212 described species (by T. Bourret). Notice the position of P. primulae selected specimen CBS 620.97 = S&T BL 50. Gloria Abad, USDA S&T.
|
|
Phytophthora spp. in subclade 8b: Morphological Tabular key (PDF) and Tabular key legends (PDF) in IDphy2 KEY SECTION. Notice the data of P. primulae selected specimen CBS 62097 = S&T BL 50. Gloria Abad, USDA S&T.
|
|
Phytophthora primulae (CPHST BL 148) colonies of the selected specimen grown for 7 days on (a) V8® Agar, (b) potato dextrose agar, and (c) malt extract agar; photo by Krysta Jennings and Leandra Knight, USDA-APHIS-PPQ |
Name and publication
Phytophthora primulae J.A. Toml. (1952)
Tomlinson JA. 1952. Brown core root rot of Primula caused by Phytophthora primulae n. sp. T. Brit. Mycol. Soc. 35: 221–235.
Nomenclature
Mycobank
Etymology
named for the species from which it was first isolated
Typification
from Tomlinson (1958)
Type: UNITED KINGDOM (ENGLAND) isolated from roots of Primula polyantha Mill. causing a stele discoloration and root rot; holotype deposited at the Herbarium Plant Pathology Laboratory, Harpenden, Herts, no. 965, type
Ex-type: LOST
Well-authenticated specimen(s) selected by Gloria Abad:
Selected specimen #1: Phytophthora primulae CPHST BL 148 = P10703 (WPC) New Zealand from Primulax polyantha Hort.
Selected specimen #2: Phytophthora primulae CPHST BL 50 = P10333 (WPC) Germany from Primula acaulis
Selected specimen #1 in other collections
(SE) CBS 62097, NRRL 64336, WPC P10333 P10220, S&T BL 50 (Abad), PD97/875, 29E9 Yang)
Molecular identification
Voucher sequences for barcoding genes (ITS rDNA and COI) of the selected specimen (see Molecular protocols page)
Phytophthora primulae isolate CPHST BL 148 (= P10703 WPC) = ITS rDNA MG865570, COI MH136962
Phytophthora primulae isolate CPHST BL 50 (= P10333 WPC) = ITS rDNA MG865571, COI MH136963
Voucher sequences for Molecular Toolbox with seven genes (ITS, β-tub, COI, EF1α, HSP90, L10, and YPT1
(see Molecular protocols page) (In Progress)
Voucher sequences for Metabarcoding High-throughput Sequencing (HTS) Technologies [Molecular Operational Taxonomic Unit (MOTU)]
(see Molecular protocols page) (In Progress)
Sequences with multiple genes for selected specimen in other sources
- NCBI: Phytophthora primulae CPHST BL 148
- NCBI: Phytophthora primulae CBS 114346
- EPPO-Q-bank: Phytophthora primulae CBS 114346
- BOLDSYSTEMS: Phytophthora primulae (barcoding COI & ITS)
Position in multigenic phylogeny with 7 genes (ITS, β-tub, COI, EF1α, HSP90, L10, and YPT1)
Clade 8b
Morphological identification
Colonies and cardinal temperatures
Colony colony:
assemblage of hyphae which usually develops form a single source and grows in a coordinated way
morphology on PDA, V8A, MEA with non-distinct pattern. Minimum growth temperature 3°C, optimum 15–21°C, and maximum 27°C.
Conditions for growth and sporulation
Hyphal swellings formed in agar or in soil water extract.
Asexual phase
SporangiaSporangia:
sac within which zoospores form, especially when water is cooled to about 10°C below ambient temperature; in solid substrates, sporangia usually germinate by germ tubes
nonpapillatenonpapillate:
pertaining to the production of a non-distinct, or inconspicuous, papilla at the distal end of the sporangium (cf. papillate and semipapillate)
; persistentpersistent:
pertaining to sporangia that remain attached to the sporangiophore and do not separate or detach easily (cf. caducous)
; ellipsoidellipsoid:
refers to a solid body that forms an ellipse in the longitudinal plane and a circle in cross section; many fungal spores are ellipsoidal or elliptic
, obpyriformobpyriform:
inversely pear-shaped, i.e. with the widest part at the point of attachment (cf. pyriform)
, ovoidovoid:
egg-shaped, with the widest part at the base of the sporangium and the narrow part at the apex
, or with irregular shapes (33–109 L x 13–39 W µm), many times showing typical constrictions, and sometimes with tapered bases; no internal proliferationinternal proliferation:
internal proliferation occurs when the sporangiophore continues to grow through an empty sporangium
is observed but external proliferationexternal proliferation:
formation of a sporangium after a sporangiophore has emerged from beneath and external to an empty sporangium that has previously emitted its zoospores (cf. internal proliferation)
originating secondary sporangiasporangia:
sac within which zoospores form, especially when water is cooled to about 10°C below ambient temperature; in solid substrates, sporangia usually germinate by germ tubes
is occasionally observed; sporangiasporangia:
sac within which zoospores form, especially when water is cooled to about 10°C below ambient temperature; in solid substrates, sporangia usually germinate by germ tubes
mostly originated on unbranched sporangiophores which often present basal and intercalaryintercalary:
positioned within a hypha (cf. terminal)
swellings. Hyphal swellings globoseglobose:
having a rounded form resembling that of a sphere
, elongate, or irregular; solitary, catenulated or toruloidtoruloid:
having swellings at intervals
kind and clustered; many times with radiating hyphaehyphae:
single, tubular filament of a fungal or oomycete thallus; the basic structural unit of a fungus or oomycete
. ChlamydosporesChlamydospores:
an asexual spore with a thickened inner wall that is delimited from the mycelium by a septum; may be terminal or intercalary, and survives for long periods in soil
absent.
Sexual phase
Homothallic. OogoniaOogonia:
the female gametangium in which the oospore forms after fertilization by the antheridium
smooth-walled; spherical to subglobose (20–50 µm diam); antheridiaantheridia:
the male gametangium; a multinucleate, swollen hyphal tip affixed firmly to the wall of the female gametangium (the oogonium)
predominantly paragynousparagynous:
pertaining to the sexual stage in which the antheridium is attached to the side of the oogonium (cf. amphigynous)
and sometimes amphigynousamphigynous:
pertaining to the sexual stage in which the antheridium completely surrounds the stalk of the oogonium (cf. paragynous)
, spherical, ovoidovoid:
egg-shaped, with the widest part at the base of the sporangium and the narrow part at the apex
, club-shaped or irregular shape, sometimes with wide antheridial hyphae; oospores aplerotic aplerotic:
pertaining to a mature oospore that does not fill the oogonium; i.e. there is room left between the oospore wall and oogonium wall (cf. plerotic)
to slightly apleroticaplerotic:
pertaining to a mature oospore that does not fill the oogonium; i.e. there is room left between the oospore wall and oogonium wall (cf. plerotic)
(17–40 µm diam). Many aborted oosporesoospores:
zygote or thick-walled spore that forms within the oogonium after fertilization by the antheridium; may be long-lived
are observed.
Most typical characters
Phytophthora primulae is characterized by the presence of typical sporangiasporangia:
sac within which zoospores form, especially when water is cooled to about 10°C below ambient temperature; in solid substrates, sporangia usually germinate by germ tubes
and hyphal swellings.
Specimen(s) evaluated
Phytophthora primulae CPHST BL 148, duplicate of P10703 (World Phytophthora Collection)
Phytophthora primulae CPHST BL 50, duplicate of P10333 (World Phytophthora Collection), same as CBS 620.97
Hosts and distribution
Distribution: Europe (UK, Denmark), New Zealand
Substrate: roots
Disease note: brown core root rot
Host: Primula spp. (Primulaceae)
Retrieved February 01, 2018 from U.S. National Fungus Collections Nomenclature Database.
Quarantine status
USA: This species was listed as a species of concern during the 2009 Phytophthora prioritization project conducted by USDA APHIS PPQ CPHST PERAL (Schwartzburg et al.).
Additional references and links
- SMML USDA-ARS: Phytophthora primulae
- EPPO Global Database: Phytophthora primulae
- Forest Phytophthora of the world: Phytophthora primulae
- CABI Digital Library: Phytophthora primulae
- Encyclopedia of Life (EOL): Phytophthora primulae
- Index Fungorum (IF): Phytophthora primulae
- Google All Phytophthora primulae
- Google Images Phytophthora primulae
- Google Scholar Phytophthora primulae
Fact sheet author
Z. Gloria Abad, Ph.D., USDA-APHIS-PPQ-S&T Plant Pathogen Confirmatory Diagnostics Laboratory (PPCDL), United States of America.